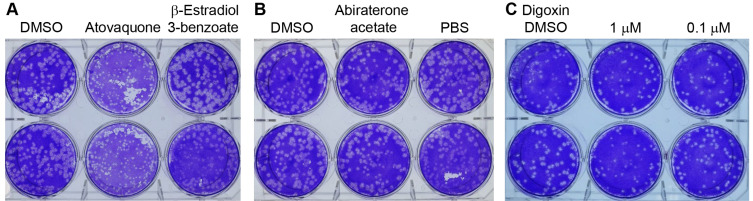

Erratum to "Abiraterone Acetate Attenuates SARS-CoV-2 Replication by Interfering with the Structural Nucleocapsid Protein" [Biomol Ther 30(5), 427-434 (2022)].
IF 3.2
3区 医学
Q2 PHARMACOLOGY & PHARMACY
引用次数: 0

“醋酸阿比特龙通过干扰结构核衣壳蛋白抑制SARS-CoV-2的复制”[j].中国生物医学工程学报,30(5),427-434(2022)。
本文章由计算机程序翻译,如有差异,请以英文原文为准。
求助全文
约1分钟内获得全文
求助全文
来源期刊
CiteScore
6.60
自引率
8.10%
发文量
72
审稿时长
6-12 weeks
期刊介绍:
Biomolecules & Therapeutics (Biomolecules & Therapeutics) (Print ISSN 1976-9148, Online ISSN 2005-4483) is an international, peer-reviewed, open access journal that covers pharmacological and toxicological fields related to bioactive molecules and therapeutics. It was launched in 1993 as "The Journal of Applied Pharmacology (ISSN 1225-6110)", and renamed "Biomolecules & Therapeutics" (Biomol Ther: abbreviated form) in 2008 (Volume 16, No. 1). It is published bimonthly in January, March, May, July, September and November. All manuscripts should be creative, informative, and contribute to the development of new drugs. Articles in the following categories are published: review articles and research articles.

 求助内容:
求助内容: 应助结果提醒方式:
应助结果提醒方式:


